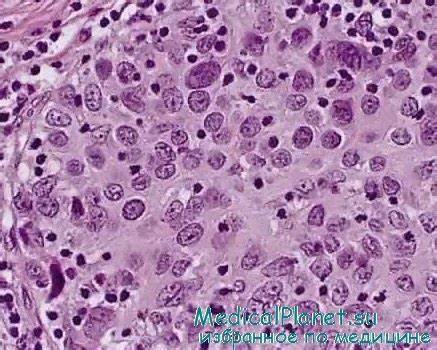
Диета рак шейки матки Классификация патоморфологии рака шейки матки. Рекомендации Классификация патоморфологии рака шейки матки. Рекомендации Диета рак шейки матки

Диета рак шейки матки
Картинка 2: Диета при раке шейки матки | Первый Медицинский Центр Тель-Авива
Картинка 3: Сеть диагностических центров МРТ ЭКСПЕРТ Сравнительная характеристика УЗИ
Картинка 4: УЗИ шейки матки: порядок проведения, показания, что можно увидеть
Картинка 5: Рак шейки матки
Картинка 6: Возможности лучевых методов диагностики в оценке состояния шейки
Картинка 7: Диета при гипотиреозе щитовидной железы: принципы правильного питания
Картинка 8: Сеть диагностических центров МРТ ЭКСПЕРТ Сравнительная характеристика УЗИ
Картинка 9: ВПЧ! Лечить или нет? Рак шейки матки и вирус папилломы человека. - YouTube
Картинка 10: Рак шейки и тела матки - презентация онлайн
Картинка 11: Картинки Рак Шейки – Telegraph
Картинка 12: Наблюдение после операции раке шейки матки
Картинка 13: Микроинвазивный рак шейки матки (стадия Ia). Критерии
Картинка 14: Классификация патоморфологии рака шейки матки. Рекомендации
Картинка 15: РАК ШЕЙКИ МАТКИ - симптомы на 1, 2 ,3, 4 стадии - YouTube
Картинка 16: УЗИ, МРТ при раке шейки матки
Картинка 17: Рак Шейки Матки Мрт
Картинка 18: Возможности МР исследований в гинекологической практике - презентация
Картинка 19: Эктопия, или эрозия шейки матки
Картинка 20: Рак шейки матки! Фотодинамическая терапия - современный метод лечения
Картинка 21: РАК ШЕЙКИ И ТЕЛА МАТКИ - СЕСТРИНСКИЙ УХОД В ОНКОЛОГИИ
Картинка 22: Презентация на тему: "РАК ШЕЙКИ МАТКИ. Рак шейки матки – это
Картинка 23: Рак Шейки Матки Фото — Картинки
Картинка 24: Папиломавирусная инфекция половых путей - презентация онлайн
Картинка 25: Длина шейки матки по неделям беременности: норма и отклонения | MedAboutMe
Картинка 26: Подозрение на рак шейки матки - Вопрос онкологу - 03 Онлайн
Картинка 27: Рак шейки матки/Операция - YouTube
Картинка 28: Мазок на цитологию шейки матки: виды исследования, как правильно сдать
Картинка 29: Инвазивный рак шейки матки - Вопрос онкологу - 03 Онлайн
Картинка 30: Рак тела матки картинки
Картинка 31: Рак шейки матки 1 стадия фото
Картинка 32: Рак шейки матки: признаки, симптомы и лечение :: SYL.ru
Картинка 33: Подозрение на рак шейка матки - Вопрос гинекологу - 03 Онлайн
Картинка 34: Рак тела матки картинки
Картинка 35: Рак шейки матки: симптомы и признаки на ранней стадии, лечение
Картинка 36: Рак шейки матки карциома - Вопрос онкологу - 03 Онлайн
Картинка 37: Рак шейки матки| Блог UNIM
Картинка 38: Рак шейки матки - YouTube
Картинка 39: Классификация, Этиология и патогенез - Рак шейки матки
Картинка 40: Рак шейки матки: симптомы, профилактика, лечение | Медицинский центр Ассута
Картинка 41: Инвазивный Плоскоклеточный Рак Шейки Матки
Картинка 42: Какие виды впч вызывают рак шейки матки - фото презентация
Картинка 43: Эрозия шейки матки - лечить или не лечить, симптомы, причины
Картинка 44: Рак шейки матки. О диагностике и лечении
Картинка 45: Анализ шейки матки на рак как назвается и зачем нужен
Картинка 46: Прогноз выживаемости при раке шейки матки
Картинка 47: Что должна знать каждая женщина про рак шейки матки - презентация онлайн
Картинка 48: Какво е рак на маточната шийка - снимки, видео
Картинка 49: Рак шейки матки - презентация онлайн
Картинка 50: Рак шейки матки - YouTube
Картинка 51: 02-34 Рак шейки матки - YouTube
Картинка 52: Рак шейки матки - YouTube
Картинка 53: Опущение шейки матки симптомы фото
Картинка 54: Как сохранить здоровье и предотвратить заболевания: рекомендации для
Картинка 55: Полезные советы | Полезные советы, Советы, Домашнее лечение
Картинка 56: Рак шейки матки: симптомы, стадии рака, лечение, прогноз операции
Картинка 57: Рак шейки матки

Диета без заморочки

Что кушать чтобы похудеть в домашних условиях список продуктов можно быстро

Диета для мочеполовой системы

Кефир с гречкой диета отзывы

Похудеть на бали

Чай ромашки похудеть

Самые эффективные упражнения чтобы убрать живот для женщин

Кто похудела за месяц 30кг

Сколько раз в день можно есть чтобы похудеть за месяц
Кето диета 7

Упражнения убрать жир с боков мужчинам

Похудеть на 30 кг за 4 месяца как

Какая диета болит поджелудочная

Диета на рис

Похудеть на много и быстро

Колики новорожденных диета мамы

Диета с отварными яйцами

Что купить поесть при диете

Внешнесекреторная недостаточность поджелудочной железы диета

Как убрать по бокам жировые складки